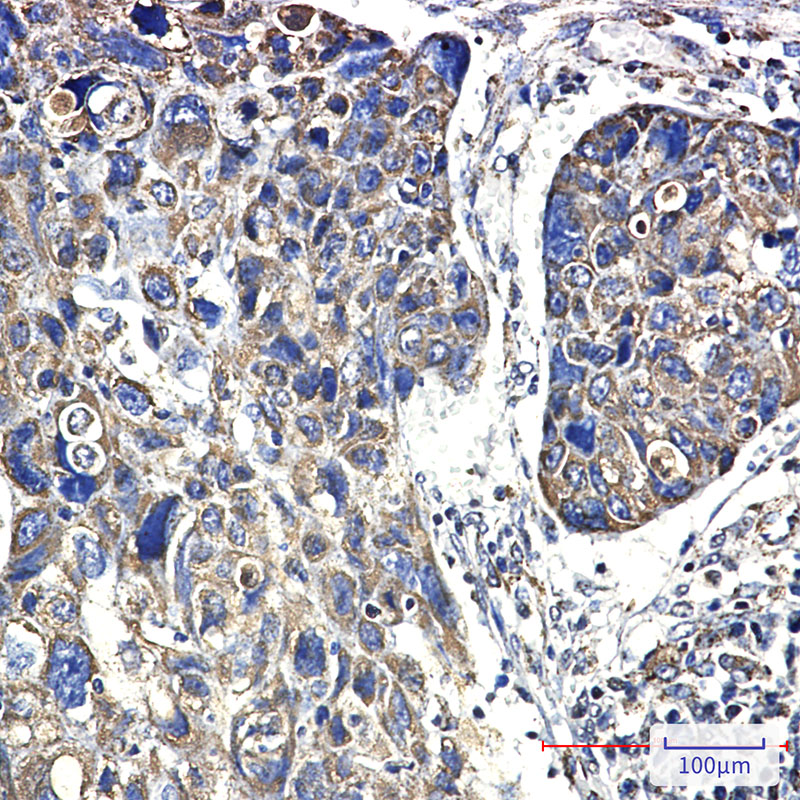

别名:HSPD1; HSP60; 60 kDa heat shock protein; mitochondrial; 60 kDa chaperonin; Chaperonin 60; CPN60; Heat shock protein 60; HSP-60; Hsp60; HuCHA60; Mitochondrial matrix protein P1; P60 lymphocyte protein应用:WB,IHC
反应种属:Human,Mouse,Rat
规格:50μl/100μl
| Description |
|---|
| HSP60 Implicated in mitochondrial protein import and macromolecular assembly. May facilitate the correct folding of imported proteins. May also prevent misfolding and promote the refolding and proper assembly of unfolded polypeptides generated under stress conditions in the mitochondrial matrix. Belongs to the chaperonin (HSP60) family. Interacts with HBV protein X and HTLV-1 protein p40tax. |
| Specification | |
|---|---|
| Aliases | HSPD1; HSP60; 60 kDa heat shock protein; mitochondrial; 60 kDa chaperonin; Chaperonin 60; CPN60; Heat shock protein 60; HSP-60; Hsp60; HuCHA60; Mitochondrial matrix protein P1; P60 lymphocyte protein |
| Entrez GeneID | 3329 |
| Swissprot | P10809 |
| WB Predicted band size | Calculated MW: 61 kDa; Observed MW: 61 kDa |
| Host/Isotype | Rabbit IgG |
| Storage | Store at 4°C short term. Aliquot and store at -20°C long term. Avoid freeze/thaw cycles. |
| Species Reactivity | Human,Mouse,Rat |
| Immunogen | A synthetic peptide of human Hsp60 |
| Formulation | 50mM Tris-Glycine(pH 7.4), 0.15M NaCl, 40% Glycerol, 0.01% Sodium azide and 0.05% BSA |
| Application | |
|---|---|
| WB | 1/500-1/1000 |
| IHC | 1/50-1/100 |
![]() |
Western blot analysis of Hsp60 in 3T3, C6, mouse heart, rat heart lysates using Hsp60 antibody. |
![]() |
Western blot analysis of Hsp60 in Hela lysates using Hsp60 antibody. |
![]() |
Immunohistochemistry analysis of paraffin-embedded Human lung cancer using Hsp60 antibody. High-pressure and temperature Sodium Citrate pH 6.0 was used for antigen retrieval. |
本公司的所有产品仅用于科学研究或者工业应用等非医疗目的,不可用于人类或动物的临床诊断或治疗,非药用,非食用。
暂无评论
本公司的所有产品仅用于科学研究或者工业应用等非医疗目的,不可用于人类或动物的临床诊断或治疗,非药用,非食用。
中文

发表回复